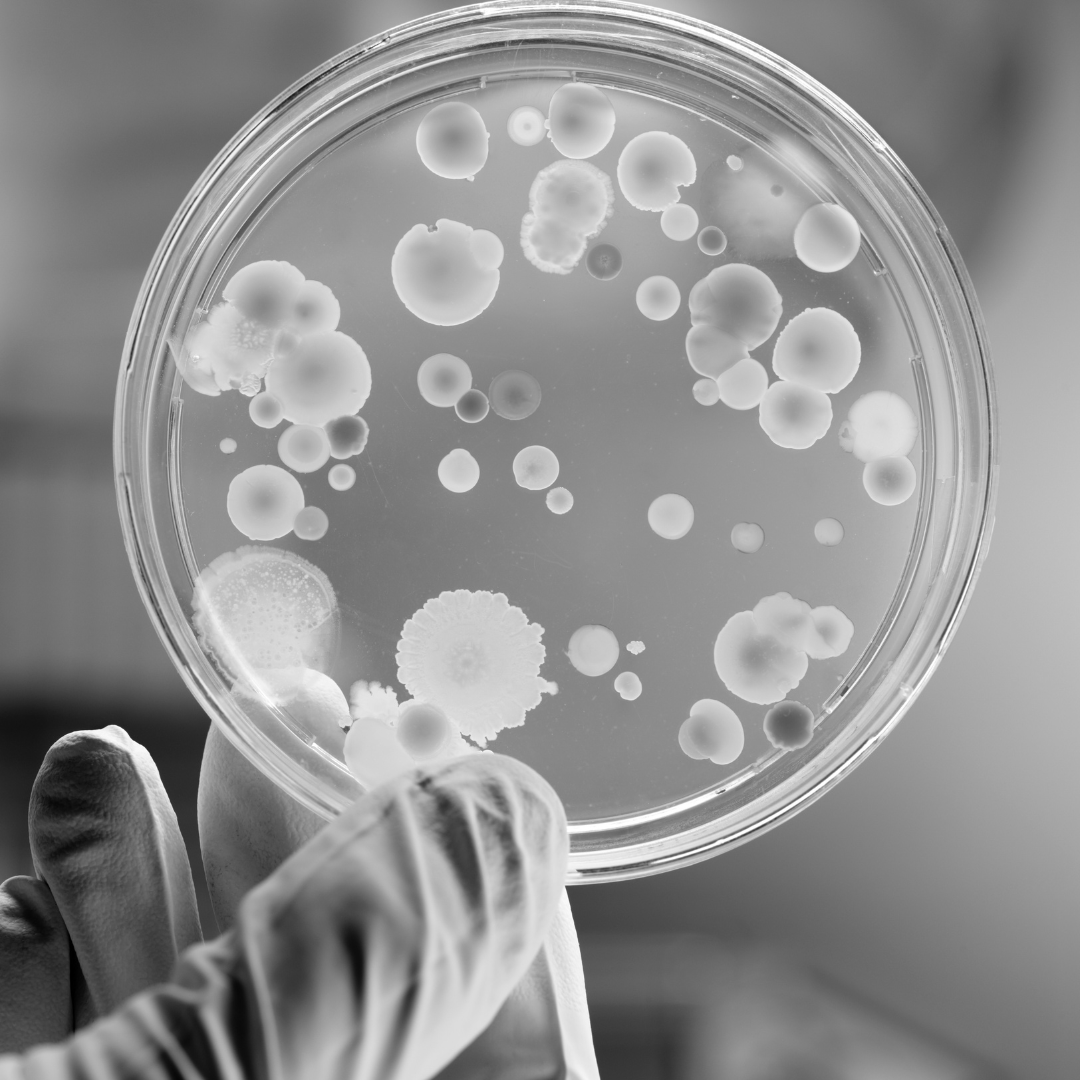

living
Probiotic Skincare

A healthier glow
Via our skin's allies
We all know the benefits of fermentation for digestive health (from gut-loving kimchi to kombucha), but now fermentation's being harnessed to improve complexions and support skin function.
Probiotic skincare contains live skin beneficial microorganisms. It works with our skin's natural ecosystem, complementing the vast community of microorganisms that lives symbiotically on our skin.
Living probiotics are set to be the next power move in skincare, as microbe biodiversity is one of the single biggest factors in the health and appearance of our skin. Our skin microbes increase lipid production (which strengthens barrier function), protect skin cells against environmental damage, and reduce harmful bacteria. Beneficial skin bacteria are also built in anti-aging superstars.
a skin wonder bug
Lactobacillus 101
Lactobacillus is found naturally on the skin in small amounts. It's linked to youthful skin and decreases over time as we get older. Benefits we get from having Lactobacillus on the skin include:
- it inhibits collagen breakdown,
- it helps protect against oxidative damage & photoaging,
- it inhibits melanin synthesis (so less pigmentation),
- it increases skin hydration,
- it reduces inflammation.
Our coconut oil for the skin is fermented by hand and certified to contain live Lactobacillus, which can help tackle skin concerns linked to microbiome dysbiosis (imbalance).

pro‧bi‧ot‧ics
living actives
(prō′bī-ŏt′ĭk)
From pro and biota, meaning "for life".
True probiotic skincare contains actual living microorganisms, which supports natural microbiome balance & diversity.
But because it's very hard to achieve the right conditions in a product that both supports viable probiotic bacteria and suppresses harmful bacteria, very few products for the skin actually contain living bacteria.
The vast majority of 'probiotic' claims in skincare are inaccurate - the microbes are in lysate form which are dead (post-biotics). These can't populate the skin or produce beneficial bioactives.
For the benefits of living microorganisms look for skincare that's scientifically validated to contain live probiotics.
